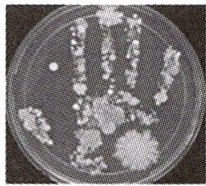

第55页
- 第1页
- 第2页
- 第3页
- 第4页
- 第5页
- 第6页
- 第7页
- 第8页
- 第9页
- 第10页
- 第11页
- 第12页
- 第13页
- 第14页
- 第15页
- 第16页
- 第17页
- 第18页
- 第19页
- 第20页
- 第21页
- 第22页
- 第23页
- 第24页
- 第25页
- 第26页
- 第27页
- 第28页
- 第29页
- 第30页
- 第31页
- 第32页
- 第33页
- 第34页
- 第35页
- 第36页
- 第37页
- 第38页
- 第39页
- 第40页
- 第41页
- 第42页
- 第43页
- 第44页
- 第45页
- 第46页
- 第47页
- 第48页
- 第49页
- 第50页
- 第51页
- 第52页
- 第53页
- 第54页
- 第55页
- 第56页
- 第57页
- 第58页
- 第59页
- 第60页
- 第61页
- 第62页
- 第63页
- 第64页
- 第65页
- 第66页
- 第67页
- 第68页
1 [2025 济南期末]蜜橘果面鲜亮,气味清香,营养丰富。但如果保存不当,时间长了会在表面上长出青绿色、绒毛状的“霉”,这些“霉”实际上是 (

A.一个细菌
B.一个真菌
C.细菌菌落
D.真菌菌落
D
)A.一个细菌
B.一个真菌
C.细菌菌落
D.真菌菌落
答案:
D
2 [2025 达州期末]小李用肉眼观察培养皿时看到如图情景:甲菌落较大且呈黑色絮状,乙菌落较小且表面光滑。下列说法正确的是 (

A.甲是细菌菌落,乙是真菌菌落
B.细菌菌落一般比真菌菌落要大
C.细菌和真菌的生存都需要一定的条件
D.观察菌落的形态特征需要用到显微镜
C
)A.甲是细菌菌落,乙是真菌菌落
B.细菌菌落一般比真菌菌落要大
C.细菌和真菌的生存都需要一定的条件
D.观察菌落的形态特征需要用到显微镜
答案:
C
3 [2025 郑州期末]康康做了检测手上微生物分布的实验,结果如图所示,下列叙述错误的是 (
A.恒温培养可为其提供适宜温度
B.从大小可判断全部为细菌菌落
C.手掌在培养基上按压的过程相当于接种
D.培养基中应含有微生物生长所需的营养
B
)A.恒温培养可为其提供适宜温度
B.从大小可判断全部为细菌菌落
C.手掌在培养基上按压的过程相当于接种
D.培养基中应含有微生物生长所需的营养
答案:
B
4 [2025 雅安期末]下列有关“检测环境中的细菌和真菌”的叙述,错误的是 (
A.在没有进行实验前,不能打开培养皿
B.必须设计一个空白实验,用来检验培养基高温灭菌是否彻底
C.接种时,要注意无菌操作
D.接种后两套培养皿应放在不同的环境中培养
D
)A.在没有进行实验前,不能打开培养皿
B.必须设计一个空白实验,用来检验培养基高温灭菌是否彻底
C.接种时,要注意无菌操作
D.接种后两套培养皿应放在不同的环境中培养
答案:
D
5 [2025 吉林期末]“吃饭前要洗手”是父母和老师让我们从小培养的卫生习惯,饭前真的需要洗手吗? 某生物兴趣小组的同学决定运用培养细菌和真菌的一般方法,设计实验进行探究。下图中,图一为小组讨论内容示意图,图二为该小组进行实验后得到的作品。请分析并回答下列问题。

(1)图一中4位同学所讨论的问题,其实是培养细菌和真菌的具体操作环节,请用4位同学的代号,将他们的操作环节按先后顺序进行排列:
(2)图一中乙同学提出“培养皿和培养基在接种前要高温处理”,目的是
(3)图一中丁同学的问题“最后能够看到的是什么?”指向了实验的结果,最终能够用肉眼看到的是细菌和真菌的
(4)图二中A培养皿与C培养皿进行
(5)该实验告诉我们
(1)图一中4位同学所讨论的问题,其实是培养细菌和真菌的具体操作环节,请用4位同学的代号,将他们的操作环节按先后顺序进行排列:
丙→乙→甲→丁
(用箭头连接)。(2)图一中乙同学提出“培养皿和培养基在接种前要高温处理”,目的是
杀死培养皿和培养基上原有的细菌和真菌,避免其对实验结果产生影响
。(3)图一中丁同学的问题“最后能够看到的是什么?”指向了实验的结果,最终能够用肉眼看到的是细菌和真菌的
菌落
。(4)图二中A培养皿与C培养皿进行
对照
,说明了洗手前手上有很多细菌
。(5)该实验告诉我们
吃饭前洗手
有利于健康。
答案:
(1)丙→乙→甲→丁
(2)杀死培养皿和培养基上原有的细菌和真菌,避免其对实验结果产生影响
(3)菌落
(4)对照 洗手前手上有很多细菌
(5)吃饭前洗手
(1)丙→乙→甲→丁
(2)杀死培养皿和培养基上原有的细菌和真菌,避免其对实验结果产生影响
(3)菌落
(4)对照 洗手前手上有很多细菌
(5)吃饭前洗手
6 创新实验 某网站曾撰文指出手机屏幕上的细菌比马桶按钮上的还多。为辨别真伪,某学习小组对此进行了探究实验,部分过程及结果如下。

(1)材料用具:三个相同的装有牛肉汁培养基的培养皿(已高温灭菌)、无菌水、试管、无菌棉棒、放大镜、恒温培养箱等。

(2)实验步骤:
步骤一:用无菌棉棒在手机屏幕一定面积上擦拭后,将无菌棉棒放入10 mL无菌水中搅拌制成菌悬液;取0.1 mL菌悬液均匀涂抹在培养基甲上,标记为甲组。
步骤二:用无菌棉棒在马桶按钮相同的面积上擦拭后,将无菌棉棒放入盛有______的试管中搅拌制成菌悬液;取0.1 mL菌悬液均匀涂抹在培养基乙上,标记为乙组。
步骤三:另取0.1 mL无菌水均匀涂抹在培养基丙上,标记为丙组。
步骤四:将三组培养基放入恒温培养箱中,一段时间后进行观察、统计。
①用无菌棉棒对手机屏幕和马桶按钮取样时,要求取样面积相同,目的是______。将菌悬液均匀涂抹在培养基上的操作相当于培养细菌和真菌实验中的______步骤。
②步骤二的空白处应填写______。
③实验中设置丙组的目的是______。
(3)实验结果如图2。根据图2结果,得出结论:______。为了增加实验的说服力,你认为可以如何改进实验? ______。
开放性设问
(4)随着时代的发展,智能手机已经成为人们生活中不可缺少的一部分,结合以上实验结果,你的建议是:______(写出一条即可)。
(2)①
(3)
(4)
(1)材料用具:三个相同的装有牛肉汁培养基的培养皿(已高温灭菌)、无菌水、试管、无菌棉棒、放大镜、恒温培养箱等。
(2)实验步骤:
步骤一:用无菌棉棒在手机屏幕一定面积上擦拭后,将无菌棉棒放入10 mL无菌水中搅拌制成菌悬液;取0.1 mL菌悬液均匀涂抹在培养基甲上,标记为甲组。
步骤二:用无菌棉棒在马桶按钮相同的面积上擦拭后,将无菌棉棒放入盛有______的试管中搅拌制成菌悬液;取0.1 mL菌悬液均匀涂抹在培养基乙上,标记为乙组。
步骤三:另取0.1 mL无菌水均匀涂抹在培养基丙上,标记为丙组。
步骤四:将三组培养基放入恒温培养箱中,一段时间后进行观察、统计。
①用无菌棉棒对手机屏幕和马桶按钮取样时,要求取样面积相同,目的是______。将菌悬液均匀涂抹在培养基上的操作相当于培养细菌和真菌实验中的______步骤。
②步骤二的空白处应填写______。
③实验中设置丙组的目的是______。
(3)实验结果如图2。根据图2结果,得出结论:______。为了增加实验的说服力,你认为可以如何改进实验? ______。
开放性设问
(4)随着时代的发展,智能手机已经成为人们生活中不可缺少的一部分,结合以上实验结果,你的建议是:______(写出一条即可)。
(2)①
保持单一变量
接种
②10 mL无菌水
③作空白对照
(3)
手机屏幕上的细菌比马桶按钮上的还多
重复实验(合理即可)
(4)
勤洗手,定期清洁手机
答案:
(2)①保持单一变量 接种 ②10 mL无菌水 ③作空白对照
(3)手机屏幕上的细菌比马桶按钮上的还多 重复实验(合理即可)
(4)勤洗手,定期清洁手机
(2)①保持单一变量 接种 ②10 mL无菌水 ③作空白对照
(3)手机屏幕上的细菌比马桶按钮上的还多 重复实验(合理即可)
(4)勤洗手,定期清洁手机
查看更多完整答案,请扫码查看